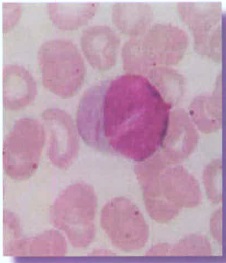

(Naranjo, 2008)
Recuperado de
Gránulos azurófilos alargados o en forma de bastón.
Encontrados en el citoplasma de los mieloblástos y contienen peroxidasa y otras enzimas.
Son el resultado anormal de los gránulos inespecíficos
Consideraciones clínicas
Leucemias mieloides
(Naranjo, 2008)
No hay comentarios:
Publicar un comentario